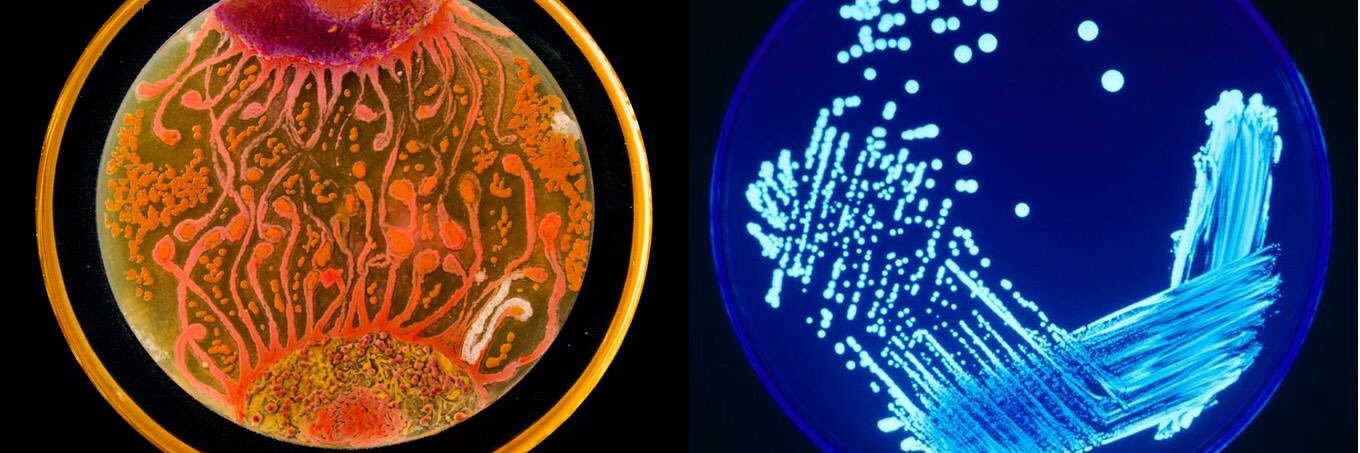
Strathclyde Biomedical Society banner

Strathclyde Biomedical Society retweetledi
Strathclyde Biomedical Society
29 posts

Strathclyde Biomedical Society
@StrathBio
Strathbiomed
Glasgow, Scotland Katılım Ekim 2018
53 Takip Edilen35 Takipçiler

@maheeenwahid @MagRoseCun Amazing news Maheen ! So so proud 💖
English
Strathclyde Biomedical Society retweetledi

We have two available PhD studentships in the area of Biopharmaceuticals for starting October 2025. Projects are collaborative between @StrathScience and @GSK. Full details within the image and at strath.ac.uk/science/chemis…
Closing date: 30th October, 2024.

English
Strathclyde Biomedical Society retweetledi

A huge welcome to all our new and returning students in the Faculty of Science!
We’re looking forward to seeing new and old faces on campus and getting stuck into this academic year. 🥼🔬🧫🧪💻🔢
#StrathLife #WelcomeWeek2024

English
Strathclyde Biomedical Society retweetledi
Strathclyde Biomedical Society retweetledi

Last spring I gave a workshop on Data Cleaning for Data Sharing Using R where we learned how to assess the quality of a dataset and apply a standardized checklist of cleaning steps in #rstats.
The slides and exercise materials are here if interested!
cghlewis.github.io/ncme-data-clea…
English
Strathclyde Biomedical Society retweetledi

A new type of microbe discovered in the human gut! Called obelisks, they can create their own proteins that are entirely new to science. The team named their proteins “oblins.” Scientists scratching their heads about it
biorxiv.org/content/10.110…

English

Hi everyone please considering following the society on Gradcracker to say up to date on placement and job opportunities! gradcracker.com/student-societ…
English
Strathclyde Biomedical Society retweetledi

Strathclyde Biomedical Society retweetledi
Strathclyde Biomedical Society retweetledi

every academic fellowship application
ely kreimendahl@ElyKreimendahl
ever since I was a little girl I knew I loved to be right
English
Strathclyde Biomedical Society retweetledi

New Society Hub on Gradcracker!
@StrathBio connects members with other passionate and motivated students with an interest in biomolecular sciences.
Visit the Hub to find out more: gradcracker.com/student-societ…

English

This might be the best thing I’ve ever seen on Twitter
Dr Katherine Baxter@KatherineBaxter
This is the best tote bag from a conference ever.
English
Strathclyde Biomedical Society retweetledi

Do you want a fully funded #internship next summer with various personal development opportunities? Sign up to join one of our webinars to discover the Saltier Scholars Programme: entrepreneurialscotland.com/events-resourc…



English
Strathclyde Biomedical Society retweetledi

⭐️ Register your interest in joining the 2025 Saltire Scholars Programme! ⭐️
Are you ready to unlock your future and take your career to the next level? We are now accepting registrations of interest for our 2025 programme!
🔗 REGISTER NOW: bit.ly/SaltireScholar…

English
Strathclyde Biomedical Society retweetledi
Strathclyde Biomedical Society retweetledi











